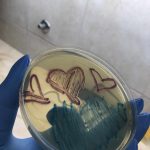
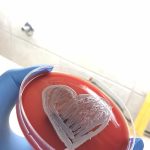

Завод за јавно здравље Шабац данас је био домаћин ученицима ОШ „Вук Караџић” из
Шапца. Ова посета представљала је значајну прилику да се ученици информишу о
раду и функцији наше установе као и да им се пружи увид о томе шта све представља
јавно здравље и какав је његов значај. Ученицима је добродошлицу испред Завода за
јавно здравље Шабац пожелеo директор наше установе МСц. др Бранко М. Вујковић
који је нагаласио да је Завод за јавно здравље Шабац, који је ове године напунио 103
рођендан, најстарија здравствена установа у Србији која се бави очувањем и
унапређењем јавног здравља, те да ученици ове школе треба да буду наши будући
партнери у стварању здравијег друштва. Током посете ученици су од стране стручњака
наше установе упознати са радом микробиолошке лабораторије која се налази у
оквиру Центра за микробиологију као и лабораторијом санитарне хемије која се налази
у склопу Центра за хигијену и хуману екологију. Начелник Центра за микробиологију
др Марина Малбашки, спец. медицинске микробиологије је покушала да ученицима
приближи свет микроорганизама којима смо окружени као и да одговори на сва питања
која су их интересовала на ову тему. Током посете ученицима се обратио и помоћник
директора за послове информисања Милош Јовановић, који је
ученике упознао са мобилном апликацијом коју је направила наша установа „Чувар
здравља“ помоћу које имају могућност да се информишу о свим параметрима
квалитета ваздуха у Шапцу у реалном времену. На овај начин је показано да пратимо
модерне токове, развој технологије као и нов начин комуникације са грађанима, а све у
циљу очувања јавног здравља.
Ова посета ученицима ОШ “Вук Караџић” из Шапца, представља прве кораке ка свету
јавног здравља и промовише сарадњу Завода за јавно здравље Шабац са образовним
институцијама подстичући значај заједничког залагања ка унапређењу здравља како
појединца тако и заједнице.